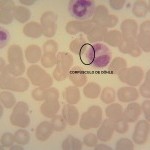
Foto da extensão sanguínea 1
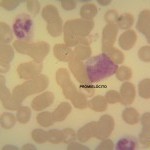
Foto da extensão sanguínea 2
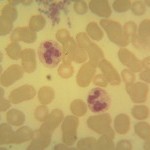
Foto da extensão sanguínea 3
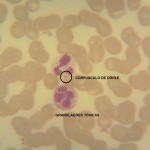
Foto da extensão sanguínea 4
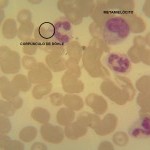
Foto da extensão sanguínea 6
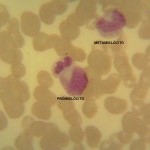
Foto da extensão sanguínea 7

Caso nº 8
Caso Clínico #10
Local: Curitiba-PR
Mês / Ano: Agosto/2014
Assuntos relacionados: INFECÇÃO BACTERIANA. SEXO MASCULINO.
Quadro Clínico
Paciente do sexo masculino, 46 anos.
Com base nos dados clínicos e laboratoriais, propomos as seguintes questões para discussão do caso:
Com base no resultado do hemograma e nas fotos da extensão sanguínea indique a hipótese diagnóstica laboratorial e faça uma breve discussão sobre sua escolha.
Referências Bibliográficas
SILVA, Paulo Henrique, et al. Hematologia Laboratorial: teoria e procedimentos. Porto Alegre, Ed. Artmed, 2016.
Dados Laboratoriais
HEMOGRAMA
-
Eritrócitos
4.580.000/uL
Hemoglobina
12,6 g/dL
Volume globular
39,0%
VCM
85,1 fL
HCM
27,5%
CHCM
32,3%
Leucócitos
14.800/uL
Plaquetas
106.000/uL
Linfócitos
03%
Monócitos
01%
Prómielócitos
01%
Mielócitos
02%
Metamielócitos
02%
Bastonetes
13%
Segmentados
78%
Neutrófilos
91%
Granulações tóxicas +++
Corpúsculos de Döhle +
Respostas da discussão
Hipótese diagnóstica laboratorial
Processo infeccioso bacteriano agudo.
Discussão do caso laboratorial
O hemograma mostra uma leucocitose discreta que se dá à custa de neutrofilia, com um discreto desvio nuclear à esquerda (13 bastonetes). Mas, o desvio nuclear à esquerda não é o mais importante, o importante é a presença de granulócitos imaturos (prómielócitos, mielócitos e metamielócitos). Além dos granulócitos imaturos há a presença de granulações tóxicas e corpúsculos de Döhle. A associação de granulócitos imaturos com granulações tóxicas e corpúsculos de Döhle caracteriza um hemograma infeccioso. Este hemograma é característico de um processo infeccioso bacteriano agudo. Como o número de leucócitos está acima do valor de referência (14.800), pode-se dizer que o quadro infeccioso é compatível com uma produção (medula óssea) maior que o consumo (tecido).
A granulação tóxica representa a visualização das granulações primárias em metamielócitos e neutrófilos (bastonetes e segmentados), células que em situações fisiológicas não tem estas granulações reveladas, em decorrência do aumento da proliferação dos neutrófilos e abreviação da mitose. Os corpúsculos de Döhle, que podem acompanhar as granulações tóxicas, são a visualização do retículo endoplasmático rugoso. O aparecimento de granulações tóxicas e corpúsculos de Döhle pode ser correlacionado com infecção bacteriana.
Outro dado relevante do hemograma é a contagem de plaquetas, que está abaixo da referência. Em um hemograma infeccioso deve-se prestar bastante atenção ao número de plaquetas. Se ocorre a queda do número de plaquetas, isto pode ser um sinal de que o paciente pode estar entrando em um quadro de septicemia. Em um hemograma infeccioso se a contagem de plaquetas está abaixo de 30.000 plaquetas/microlitro o paciente, quase que com certeza, está em um quadro de septicemia.